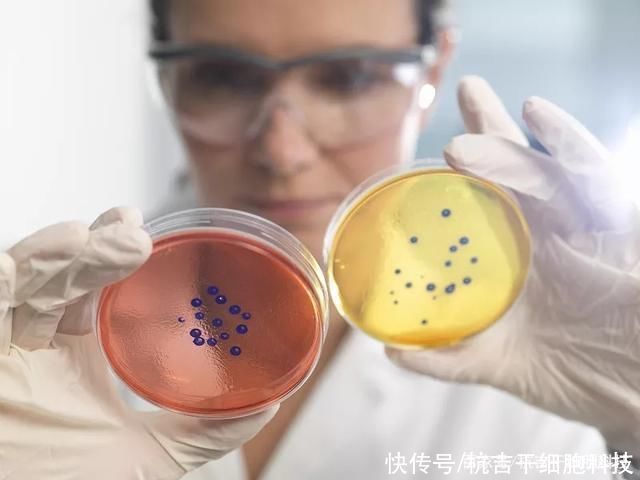
干细胞|干细胞疗法对糖尿病相关病变的临床试验

干细胞|干细胞疗法对糖尿病相关病变的临床试验( 二 )
在安全性方面,1例患者在MSCs移植术后出现局部血液外渗,并于1周后症状消失。 在整个研究期间,未发生严重低血糖事件。至随访结束,PET-CT未发现任何患者身体异常。
文章插图
展望
【 干细胞|干细胞疗法对糖尿病相关病变的临床试验】综上所述,MSCs具有多分化潜能、免疫调节作用、易获取和无伦理学问题等优势,对DM的治疗效果良好。MSCs移植有望成为一种高效、理想的治疗DM及其并发症的方法,且其应用领域将逐步扩大。
- 按摩|你知道吗?间充质干细胞可以改善失眠症状
- 病例|河南省疾控中心提醒:应对奥密克戎,这件事很重要!
- 国人历来重视精神对治疗疾病、养生保健的重要作用|心平气和,有益健康的“良药”
- 原来痛风的发作与这些因素有关,中医告诉你缓解痛风的好疗法
- 救治|广东珠海:奥密克戎感染后症状相对较轻 新增病例年轻人偏多
- 丝瓜|常吃丝瓜对身体好,但丝瓜不能与一物同吃,爱吃的人得忌口了!
- 德尔塔|珠海:奥密克戎感染后症状相对较轻,新增病例年轻人偏多
- 浴室里的“它”,可能是癌症帮凶,多数人洗澡时比较喜欢用
- 德尔塔|广东珠海:奥密克戎感染后症状相对较轻 新增病例年轻人偏多
- 那过|孕期吃药对胎儿有没有影响
